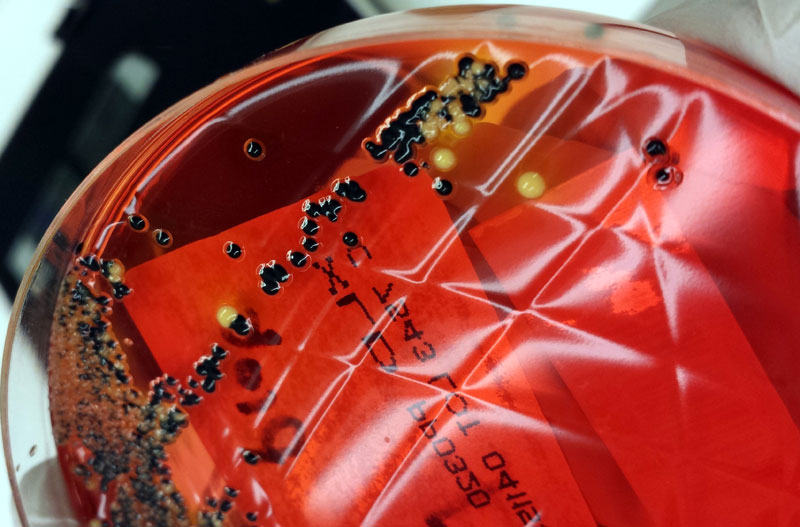

• la secţia de Oftalmologie din cadrul SJU Brăila intervenţiile chirurgicale au fost puse pe pauză timp de aproape două săptămâni, iar acum se fac cu programare, după ce la patru pacienţi operaţi de cataractă s-a descoperit o infecţie cu bacteria Proteus • ghinioniştii au ajuns la Bucureşti ca să scape de infecţie • imediat după depistarea cazurilor, conducerea spitalului a impus reguli mai stricte în ceea ce priveşte intervenţiile chirurgicale • măsurile luate au dus la reducerea numărului de operaţii care se pot face într-o zi, fapt ce îi nemulţumeşte pe brăileni • de la începutul anului, conform DSP, au fost raportate 28 de infecţii asociate îngrijirilor medicale, dintre care 24 numai la Spitalul Judeţean
Infecţiile intraspitaliceşti au ridicat gradul de alarmă la Spitalul Judeţean de Urgenţă Brăila, după ce mai mulţi pacienţi operaţi de cataractă s-au întors la spital din cauza infecţiilor contactate din unitatea medicală cu bacteria Proteus. Timp de câteva săptămâni, la secţia de Oftalmologie nu s-au mai operat bolnavii cronici, ci doar urgenţele, iar urmare a protocolului strict introdus în Blocul Operator, pe parte de curăţenie, numărul de operaţii a scăzut, ajungându-se la amânări chiar şi cu două săptămâni a intervenţiilor programate. Episodul de infecţie cu bacteria Proteus a fost confirmat de conducerea SJU Brăila, precum şi de către Direcţia de Sănătate Publică (DSP). Imediat după depistarea infecţiilor s-a demarat o anchetă epidemiologică, dar probele recoltate din spital au ieşit negative. Conducerea unităţii spitaliceşti a impus în paralel reguli mai stricte privind prevenirea şi controlul infecţiilor nosocomiale, care acum, printr-un ordin al Ministerului Sănătăţii, se numesc “infecţii asociate îngrijirilor medicale”. De la începutul anului, DSP Brăila a confirmat nu mai puţin de 28 de cazuri de infecţii asociate îngrijirii medicale, majoritatea covârşitoare fiind înregistrată la Spitalul Judeţean.
Infecţiile intraspitaliceşti există în toate spitalele din România, iar cele din Brăila nu fac excepţie. În luna septembrie, la secţia de Oftalmologie din cadrul Spitalului Judeţean de Urgenţă (SJU) Brăila nu s-au operat bolnavii cronici timp de aproape două săptămâni după ce la mai mulţi pacienţi a fost descoperită o infecţie. Aceştia au fost operaţi de cataractă şi la circa o săptămână de la externare s-au întors la spital unde s-a descoperit că aveau o infecţie cu bacteria Proteus. Episodul ne-a fost semnalat printr-o sesizare de către mai mulţi cititori “Obiectiv Vocea Brăilei” şi nu mică ne-a fost mirarea când reclamaţiile s-au confirmat. Mai precis, în cursul lunii septembrie am primit o sesizare pe adresa redacţiei prin care ni se aducea la cunoştinţă faptul că la Secţia de Oftalmologie din cadrul Spitalului Judeţean de Urgenţă Brăila nu se mai fac intervenţii chirurgicale după ce mai mulţi pacienţi ar fi luat infecţii din spital. Am luat legătura cu directorul medical şi purtătorul de cuvânt SJU Brăila, dr. Alina Neacşu, care ne-a confirmat că au fost câteva astfel de cazuri şi că timp de aproape două săptămâni nu s-au operat decât urgenţele. Imediat după descoperirea lor conducerea spitalului a impus reguli mai stricte privind prevenirea şi controlul infecţiilor nosocomiale. De altfel, la începutul lui septembrie şi Ministerul Sănătăţii a adoptat un act legislativ prin care reglementează aceste infecţii.
Revenind pe plan local, în luna august, patru pacienţi, cu vârste înaintate, au mers la Spitaul Judeţean să îşi făcă o operaţie de cataractă. Ei au fost externaţi şi după o săptămână au revenit la spital cu infecţii la ochi şi s-a descoperit că au contactat bacteria Proteus. Povestea a fost confirmată şi de conducerea DSP Brăila. Concret, în statisticile Direcţiei se arată că, în luna august, s-a raportat un focar de endoftalmită clinic cu patru cazuri la secţia de Oftalmologie.
“Au fost patru pacienţi care au venit şi s-au operat pentru cataractă. După operaţie ei au fost externaţi şi cam la o săptămână s-au întors la spital şi a fost depistată această bacterie. Pacienţii au fost redirecţionaţi la secţii de specialitate oftalmologie din Bucureşti. Vorbim despre patru oameni în vârstă care mai aveau şi alte afecţiuni pe lângă cataractă. Activitatea a fost suspendată timp de aproape două săptămâni şi în acea perioadă nu s-au operat decât urgenţele iar pacienţii cronici au fost reprogramaţi”, ne-a declarat dr. Alina Neacşu.
Imediat după ce s-au descoperit aceste infecţii, Serviciul pentru Prevenirea şi Controlul Infecţiilor Nosocomiale (SPCIN) a început o anchetă epidemiologică.
“A fost o perioadă de aproape două săptămâni în care am făcut investigaţii să vedem care au fost cauzele care au dus la apariţia acestor infecţii, astfel încât ele să nu se mai repete pe viitor. Am raportat infecţiile SPCIN care au venit şi au luat probe de peste tot, din sală, de pe mâinile noastre, de pe mâinile asistentelor, din apa de la sterilizare, de pe instrumente etc. Probele au ieşit negative. Nu am niciun fel de probă care să îmi incrimineze spitalul. Şi s-au luat probe de mai multe ori”, a adăugat sursa citată.
În paralel cu ancheta desfăşurată de SPCIN, conducerea Spitalului Judeţean a revizuit toate protocoalele privind intervenţiile chirurgicale şi s-a modificat inclusiv protocolul de internare al pacienţilor. Totodată, s-a adoptat un plan de măsuri privind controlul şi prevenirea infecţiilor asociate îngrijirilor medicale (nosocomiale) care vizează întreg Blocul Operator, Sterilizarea, sălile de operaţie şi secţiile. Mai mult, aşa cum ne-a declarat dr. Alina Neacşu, după focarul de infecţii de la Oftalmologie s-a adoptat şi un plan de măsuri cu scopul de a limita vehicularea germenilor şi a prevenirii infecţiilor nosocomiale. Prin acesta se modifică programul intervenţiilor, care începe la 7.30 dimineaţa, iar numărul şi tipul intervenţiilor se comunică cu o săptămână înainte, astfel încât toţi medicii ştiu din timp câţi pacienţi au de operat şi la ce ore. În ceea ce priveşte personalul mediu şi auxiliar, acesta îşi îndeplinişte sarcinile de serviciu strict în cadrul Blocului Operator, adică nu mai iese nimeni din sala de operaţie odată ce s-a intrat, iar pregătirea sălii cu materiale medico-sanitare se va face în timpul de repaos dintre intervenţii. O altă măsură prevăzută în plan este creşterea numărului de şedinţe (două pe lună) de instruire a personalului medical privind respectarea procedurilor de lucru.
“La secţia de Oftalmologie se fac în jur de 2.000 - 2.200 de intervenţii chirurgicale într-un an. Dintre acestea 75% sunt pe partea de bolnavi cronici şi 25% pe partea de urgenţă. Ca orice altă disciplină chirurgicală este supusă tuturor riscurilor şi sunt diverşi factori care pot genera aceste infecţii iar pacientul semnează un consimţământ prin care îşi asumă acest risc. Ele sunt peste tot în lumea asta, chiar şi în cele mai bune spitale. Infecţiile nosocomiale nu au crescut după Colectiv ca număr ci a crescut numărul declarat al lor. Infecţiile au fost, sunt şi vor mai fi. Important este să le identificăm şi să luăm măsuri pentru a nu se repeta”, a precizat directorul medical SJU Brăila.
Reguli mai stricte, operaţii mai puţine
În prezent la SJU Brăila sunt 5 săli de operaţie, săli în care fac intervenţii chirurgicale medicii de la toate specializările. Programul pentru bolnavii cronici începe la ora 7.30 dimineaţa şi se termină la ora 14.00. Desigur, acesta poate suferi modificări în funcţie de urgenţele care apar. Cum Blocul Operator este, încă, în reparaţii şi noile reguli privind prevenirea infecţiilor intraspitaliceşti presupun un anumit timp pentru pregătirea sălilor de operaţii, numărul intervenţiilor care se pot face într-o zi s-a redus, fapt ce stârneşte nemulţumiri în rândul pacienţilor.
“Cu noile prevederi care au apărut ca urmare a infecţiilor nosocomiale am limitat numărul de operaţii. Ce vrea să însemne asta? Între operaţii trebuie respectat un anumit timp pentru pregătirea sălii. Operaţia durează de la ora x până la ora y, după aceea se face curăţenie, după aceea sala se dezinfectează şi stă un timp cu substanţele apoi se intră cu următoarea operaţie. Din cauza asta, la Oftalmologie, în loc să se facă câte operaţii se făceau pe zi se fac acuma cu 7-8 mai puţine că durau mai puţin astea de cataractă. Prin urmare s-au făcut liste de programare şi oamenii sunt nemulţumiţi că erau văzuţi azi şi operaţi mâine. Acum sunt programaţi şi trebuie să aştepte o săptămână, două, până când le vine rândul la operaţie. E o normalitate asta. Adică respectăm în acest moment toate criteriile de prevenire a infecţiilor nosocomiale şi la capacitatea pe care o avem în momentul ăsta, cu Blocul Operator în reparaţie, este maximum ce putem face. Când ne mutăm o să avem mai multe săli şi o să fie mai lejer. Acolo sala aia este împărţită între Oftalmologie şi Neurochirurgie. Din momentul infecţiilor de la Oftalmologie am instituit nişte măsuri foarte stricte în tot Blocul Operator”, ne-a declarat dr. Mihail Iugulescu, manager SJU Brăila.
Bacteria Clostridium face victime şi în Spitalul 3
În altă ordine de idei, zilele trecute, o nouă sesizare a venit pe adresa redacţiei, fiind reclamat cazul unei brăilence adusă cu Salvarea la Spital, în plin episod de diaree acută, din cauza, spun rudele femeii, unei infecţii cu bacteria Clostridium, contactată în Spitalul 3, în urma unei clisme administrată cu instrumentar nesteril. “Mama mea, Balea Joiţa, a fost internată acum 3 săptămâni la Spitalul 3, secţia gastroenterologie, unde i s-a făcut o clismă folosindu-se instrumentar nesterilizat. Spun asta pentru că instrumentarul nu a fost deschis din ambalajul steril în faţa noastră. Sau măcar să ne fi spus că mergeam noi să cumpărăm toate cele necesare. Ne-a externat, iar după ce am ajuns acasă cu ea, a avut în continuu diaree. Abia aşa am făcut legătura cu ce se întâmplase la Spitalul 3. Am chemat Salvarea şi am ajuns din nou la Spitalul 3, la aceeaşi secţie, unde după ce i s-a făcut analiza de coprocultură a venit şi confirmarea că fusese infectată cu această bacterie Clostridium. Astăzi (ieri - n.r.) mama mea a fost preluată din nou cu salvarea de la Spitalul 3 şi suntem acum internaţi la Secţia Infecţioase de la Spitalul Judeţean”, ni s-a plâns fiica femeii, Calomfira Măcreanu.
Statistică DSP Brăila: 28 de infecţii nosocomiale în primele nouă luni ale anului
Conform unei statistici a DSP Brăila, în anul 2015 au fost 44 de cazuri de infecţii nosocomiale la Spitalul Judeţean de Urgenţă Brăila, singurul care a raportat numărul lor. Cauzele infecţiilor au fost digestive - 30, plagă chirurgicală - 7, cutanate - 5, infecţie urinară - 1, infecţii respiratorii - 1. Precizăm că anul trecut nu s-a raportat niciun focar de infecţie.
Anul acesta, în primele nouă luni, s-au raportat 28 de cazuri de infecţii asociate îngrijirii medicale, dintre care 24 la Judeţean, una la Spitalul de Psihiatrie şi 3 la Spitalul de Pneumoftiziologie. La SJU Brăila au fost raportate 14 infecţii digestive, 2 infecţii respiratorii, 4 infecţii plagă chirurgicală şi 4 infecţii din alte cauze. În această statistică intră şi focarul de infecţii de la secţia de Oftalmologie. La Spitalul de Psihiatrie “Sf. Pantelimon” s-a raportat o infecţie cutanată, iar la TBC, 3 infecţii digestive. Pentru toate infecţiile intraspitaliceşti au fost întreprinse măsuri specifice de către Serviciul pentru Prevenirea şi Controlul Infecţiilor Nosocomiale.
Reguli mai stricte pentru prevenirea infecţiilor
În luna septembrie, Ministrul Sănătăţii a adoptat o serie de reguli tehnice privind curăţarea, dezinfecţia şi sterilizarea în spitalele româneşti. Este vorba despre OMS nr. 961/2016 care reprezintă primul act normativ din pachetul legislativ privind controlul infecţiilor nosocomiale. Prin acest ordin, conform recomandărilor Comisiei Europene, termenul de “infecţii nosocomiale” se redefineşte şi devine “infecţii asociate îngrijirilor medicale”. Conţinutul actului cuprinde normele tehnice privind curăţarea, dezinfecţia şi sterilizarea în spitale; tehnica de lucru şi de interpretare pentru testele care evaluează eficienţa curăţeniei şi a dezinfecţiei; procedura recomandată pentru igiena şi dezinfecţia mâinilor personalului din spitale; metodele de aplicare a dezinfectanţilor chimici în funcţie de suportul care urmează a fi tratat; metodele de evaluare a derulării şi eficienţei procesului de sterilizare.
Pe lângă aceste norme tehnice, la achiziţia de produse de curăţenie şi dezinfecţie, toate spitalele sunt obligate să solicite avizul Comisiei Naţionale de Produse Biocide şi rezultatele testelor de eficacitate în baza cărora a fost emis avizul pentru produsul respectiv.
În ceea ce priveşte testele de autocontrol din unităţile sanitare, acestea vor fi efectuate cu o frecvenţă care trebuie să ţină cont de zonele de risc din spital, circulaţia germenilor în unitate şi rezultatele screening-ului la pacienţi.